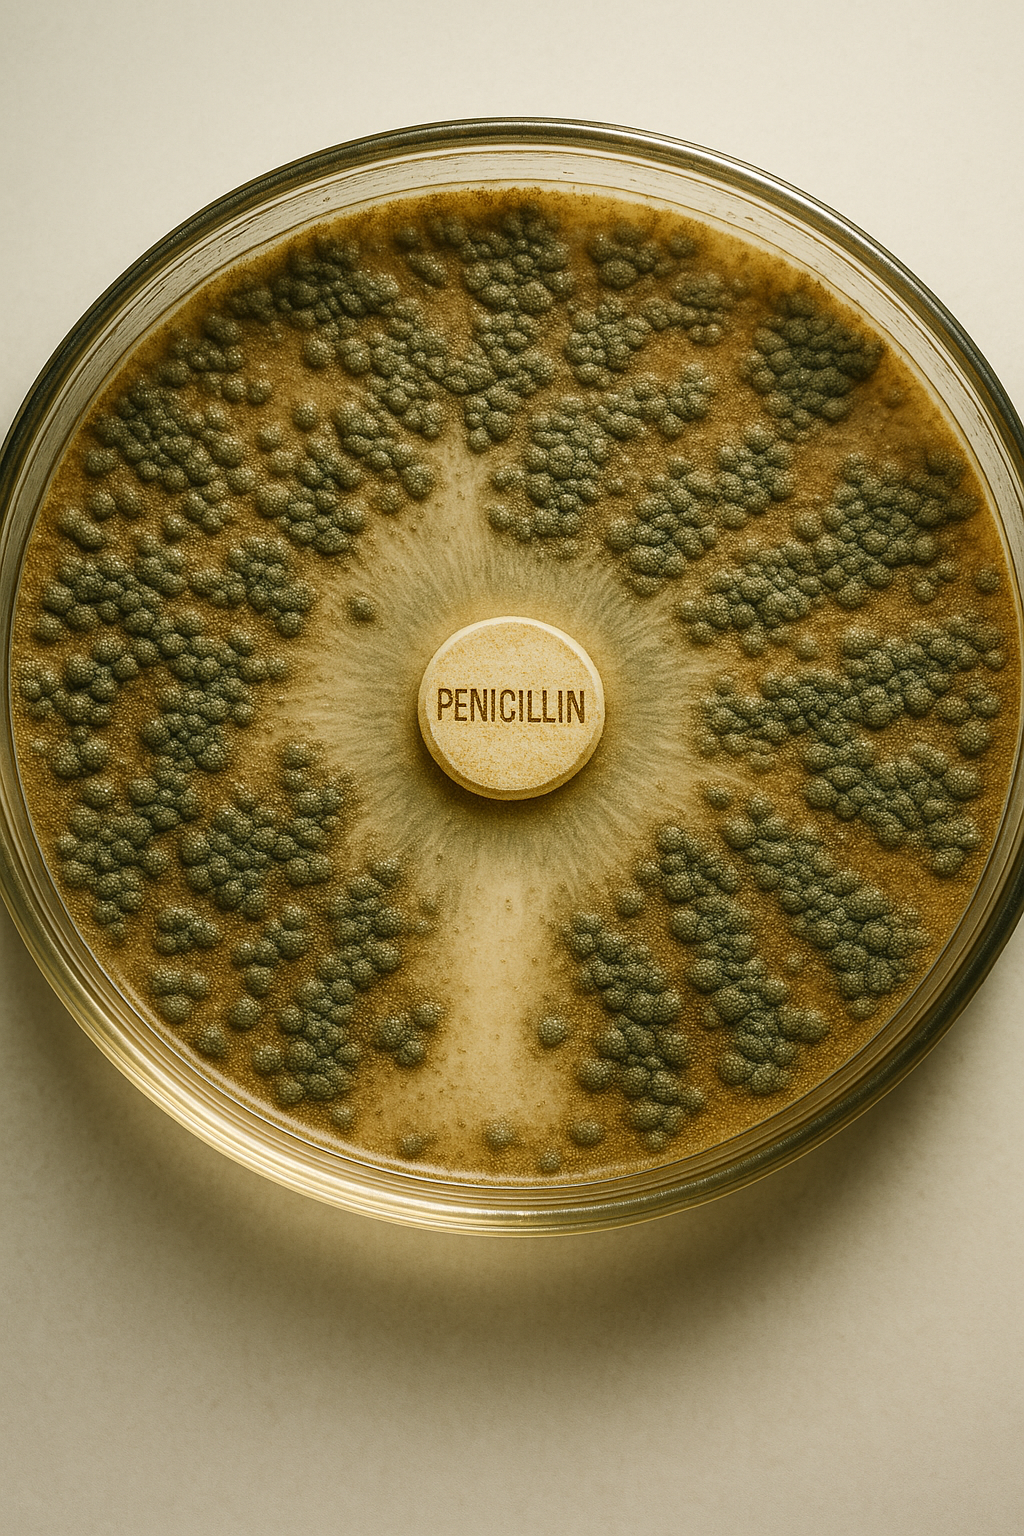
페니실린

반응형
📌 오늘의 기념일
- 체코 국가정체성의 날 (체코)
9월 28일을 성 바츨라프 축일이자 국가 정체성을 기리는 국경일로 운용한다. 공공기관은 중세 보헤미아의 정치·종교사와 근대 민족운동의 연속성을 전시·강연으로 정리한다. 학교와 박물관은 상징·의례·문화유산 관리 기준을 주제로 시민 교육을 진행한다. - 스승의 날·공자 탄신일 (대만)
대만은 9월 28일을 공자 탄신일로 기념하며 교사 존중 문화를 강조한다. 지방정부와 학교는 모범 교원 포상, 공개 수업, 교육 혁신 사례 공유를 운영한다. 문화기관은 유가 전통과 현대 교육제도의 접점을 주제로 전시·세미나를 연다. - 정보에 대한 보편적 접근의 날 (UN)
공공정보 접근권과 투명한 거버넌스의 가치를 알리는 국제기념일이다. 정부·의회·사법부는 정보공개 제도 운영과 데이터 표준을 점검한다. 시민사회는 정보 권리 교육과 사례 조사로 제도 개선 과제를 제시한다. - 세계 광견병의 날 (국제)
인수공통감염병인 광견병 예방을 위한 백신 접종과 감시 체계를 강조한다. 보건기관은 반려동물 등록·접종률 제고, 노출 후 예방요법 안내를 집중 홍보한다. 교육기관과 지자체는 위험지역 관리, 유기동물 대응, 교차 보고 체계를 점검한다. - 국제 안전한 임신중절의 날 (국제)
재생산 건강과 안전한 의료 접근의 중요성을 조명한다. 각국 단체는 법·의료·교육의 연계를 통해 지침과 상담망을 안내한다. 연구기관은 통계·보건지표를 활용해 근거 기반 정책을 논의한다. - 내셔널 굿 네이버 데이 (미국·비공식)
지역사회 내 이웃 간 협력과 상호 존중을 장려하는 비공식 기념일이다. 지방정부와 커뮤니티는 공동체 안전, 상호부조, 생활환경 개선 프로젝트를 운영한다. 교육기관은 시민성·갈등 조정 훈련을 병행한다.
🕰 역사 속 오늘
① 고대~19세기
- 기원전 48 – 폼페이우스 피살 (이집트)
카이사르와의 내전에서 패한 그나이우스 폼페이우스가 이집트 해안에 상륙한 직후 정치적 계산에 따라 살해되었다. 알렉산드리아 궁정은 로마 내전에 대한 개입과 관계 재설정을 동시에 고려했고, 사건은 로마 공화정 말기의 권력 재편 속도를 가속했다. 이후 카이사르는 이집트 문제와 동부 전선을 병행 처리하며 행정·군사 자원을 집중했고, 로마의 대외정책은 개인 권력 기반을 중심으로 재구성되었다. 사건 기록은 외교적 망명과 호송, 종속 왕국의 자율 공간이 얼마나 제한적인지 보여 주는 사례로 남는다. - 1066 – 노르만 원정군 잉글랜드 상륙 (잉글랜드)
윌리엄 공이 페번지 해안에 상륙해 보급 거점을 확보했다. 이동·상륙·진지 구축이 빠르게 진행되며 현지 자원 조달과 방어선 탐색이 병행되었다. 북부에서 노르웨이군을 격파한 잉글랜드군은 강행군 이후 재정비 시간이 부족했고, 남하 중인 노르만군과의 충돌 조건이 형성되었다. 상륙 이후의 작전은 해상 운송, 정찰, 사기 유지, 공병 투입 같은 요소의 결합으로 전개되었고, 수주 뒤 전투의 승패가 섬의 통치 질서를 바꾸는 계기가 되었다. - 1106 – 팅셰브레이 전투 (노르망디)
헨리 1세와 로베르 2세가 충돌한 전투에서 왕권 강화와 영토 지배 구조가 재정의되었다. 지휘체계 통일과 기병·보병의 협동 운용이 우세를 만들었고, 포로 처리와 봉신 관계 재편이 뒤따랐다. 전투의 결과는 잉글랜드·노르망디 결합 통치의 기반을 공고히 했으며, 법·재정 권한의 집중도 심화되었다. 이후 가문 내 계승 규칙과 대외 동맹의 조정이 이어졌다. - 1322 – 뮐도르프 전투 (독일)
바이에른의 루트비히 4세와 합스부르크의 프리드리히 1세가 충돌해 루트비히가 승리했다. 전투는 제후 연합의 동원력, 기사·보병 비율, 포로 협상 규범이 결합된 근세 초기 군사 운영의 전형을 보여 준다. 패배 측의 권력 기반은 약화되었고, 제국 내 주도권과 선제후 협의 구조가 재정렬되었다. 이후 황위 분쟁과 교황권과의 관계도 재조정되었다. - 1542 – 카브리요, 캘리포니아 연안 도달 (스페인)
후안 로드리게스 카브리요가 오늘날 샌디에이고 만에 이르는 항해를 기록했다. 탐사는 해류·해안선·접안지 정보와 토착 공동체에 대한 관찰을 축적했고, 이후 항해·교역·군사 거점 구상의 참조 자료가 되었다. 접촉은 동맹·중재·충돌이 교차하는 장면을 만들었고, 식민 통치의 제도화로 연결되었다. 지리 정보의 표준화와 항해 일지 관리도 강화되었다. - 1781 – 요크타운 포위전 개시 (미국)
프랑스·미국 연합군이 요크타운에 집결하여 포위 진지를 구축했다. 포병 배치, 참호 진출, 보급선 보호가 핵심 과제로 설정되었고, 해상 봉쇄와 육상 포위의 연동이 전황을 좌우했다. 연합 지휘 체계와 통역·연락 절차가 정비되며 공성 단계가 단계적으로 진행되었다. 포위전의 전개는 전쟁 종결을 재촉하는 정치·외교적 압박으로 이어졌다. - 1864 – 국제노동자협회 창립 (영국)
런던에서 다양한 노동·정치 그룹이 결집해 국제적 연대를 표방하는 조직이 출범했다. 규약은 조합 활동, 연대 기금, 파업 지원, 이동 노동자 보호를 포함했다. 도시 산업화의 조건과 국가별 법제 차이를 넘는 정보 교환체계가 마련되었고, 회의·출판·통계를 통한 운동의 표준화가 시도되었다. 이후 각국 사회운동의 조직화 방식과 정책 의제가 변했다.
② 20세기 이후
- 1928 – 페니실린 효과 관찰 기록 (영국)
알렉산더 플레밍이 배양 접시에 생긴 푸른곰팡이가 주변 세균 증식을 억제한다는 사실을 9월 28일자로 관찰·기록했다. 이 관찰은 항생제 개발의 출발점이 되었으며, 정식 학술 발표는 1929년에 이루어졌다. 이후 정제·대량생산·임상 적용 과정에서 화학·공정·임상시험 설계가 정교화되었다. 전시 보급과 전후 보건정책은 감염 치명률을 크게 낮췄고, 항생제 내성 관리라는 새로운 과제를 동반했다. 의약·농축산·기초 생물학 영역 전반의 연구 표준도 함께 변했다. - 1939 – 바르샤바 항복, 폴란드 전역의 전황 전환 (폴란드)
9월 1일 침공 이후 지속된 포격과 포위로 수도가 9월 28일 항복했다. 도시는 식수·식량·의료 자원 부족과 민간 피해가 누적되었고, 군사·행정 지휘계통은 후퇴·항전·지하조직의 선택을 분화시켰다. 항복은 망명정부 수립과 연합국과의 협력 체계를 촉발했고, 점령 행정과 인권 침해의 장기 문제가 뒤따랐다. 전쟁 수행의 산업·물류 기반 재편이 전역으로 확산되었다. - 1958 – 프랑스 공화국 헌법 국민투표 실시 (프랑스)
제5공화국 헌정 질서를 확립하는 개헌안이 대규모 국민투표에 부쳐졌다. 대통령 권한 강화와 내각 책임의 분배가 제도화되었고, 해외 영토의 지위와 자결 문제도 연동되었다. 결과는 행정 안정과 식민지 정책의 변화, 경제 기획 체계의 정비로 이어졌다. 투표·개표·감사 절차의 표준화가 선거관리의 기준이 되었다. - 1961 – 시리아, 아랍연합공화국 이탈 쿠데타 (시리아)
군부 세력이 9월 28일 정권을 장악해 연합국가 체제를 종료했다. 행정·재정·군사 통합의 불균형과 정책 갈등이 누적된 결과로 평가되며, 분리 이후 외교 노선과 경제 정책의 재정립이 추진되었다. 국내 정치 세력의 재편과 언론·사법의 위치도 변했다. 지역 정세와 동맹 구조에 연쇄 영향을 남겼다. - 1978 – 교황 요한 바오로 1세 선종 (바티칸)
즉위 한 달 남짓 만에 교황이 선종했고, 교황권 운영과 곤조르의 절차가 신속히 가동되었다. 사후 평가는 사목 노선, 교회 행정 개혁 방향, 외교·대화 정책의 연속성 문제를 점검했다. 전례·장례·기록 관리가 표준에 따라 진행되었고, 후임 선출 과정은 교회법 규범에 따라 시행되었다. 단기 재임의 행정 연속성을 확보하는 장치의 필요성도 확인되었다. - 2000 – 제2차 인티파다 발단 (팔레스타인·이스라엘)
9월 28일 성지 방문을 계기로 시위와 충돌이 급격히 확산되었다. 이후 수년간 치안·검문소·정착촌·장벽 등 여러 정책 변화가 이어졌고, 국제 중재 시도와 휴전 논의가 반복되었다. 경제·교육·보건 접근성의 악화가 인도주의 의제로 부상했으며, 지역 안보 환경과 외교 관계도 변화했다. 분쟁 관리 메커니즘의 한계가 드러났다. - 2008 – 스페이스엑스 ‘팰컨 1’ 첫 궤도 비행 성공 (미국)
민간 개발 로켓이 9월 28일 궤도에 진입하면서 저비용·모듈형 발사체 개발의 타당성이 입증되었다. 시험 비행의 실패 경험이 설계·품질·시험 절차 개선으로 연결되었고, 추진·유도·소프트웨어 검증 표준이 보완되었다. 상업 발사 시장 구조와 계약 모델이 재편되었으며, 후속 발사체 개발·재사용 기술의 투자 확대를 촉진했다. 공급망·인력·규제 협업도 고도화되었다. - 2014 – 홍콩 ‘우산 운동’ 대규모 시위 확산 (홍콩)
선거 제도 개편안에 대한 반대 시위가 9월 28일 대규모로 확산되었다. 도심 주요 구역에서 집회가 이어지며 교통·상권·치안 운영에 큰 변동이 발생했고, 행정 당국과 시위대 간 교섭·집행 절차가 쟁점이 되었다. 정보 확산과 조직 방식은 온라인 플랫폼 의존도가 높았고, 시민 참여의 지속성·분화가 나타났다. 이후 제도 변화와 공공질서 규범 논의가 이어졌다. - 2018 – 술라웨시 지진·지진해일 발생 (인도네시아)
9월 28일 강진과 연쇄 지진해일이 파롈루만을 중심으로 피해를 남겼다. 단층 운동과 지형 조건이 복합 작용하며 액상화와 구조물 붕괴가 광범위하게 나타났다. 긴급 구조·이재민 지원·인프라 복구가 단계적으로 진행되었고, 조기경보·토지이용·내진 설계 기준 개선이 정책 과제로 부상했다. 국제 공조와 재정 조달 메커니즘도 점검되었다.
반응형
'오늘을 읽다,보다,느끼다 > 오늘의역사' 카테고리의 다른 글
| 📅 9월 30일 오늘의 역사 (0) | 2025.09.29 |
|---|---|
| 📅 9월 29일 오늘의 역사 (0) | 2025.09.28 |
| 📅 9월 27일 오늘의 역사 (0) | 2025.09.26 |
| 📅 9월 26일 오늘의 역사 (0) | 2025.09.25 |
| 📅 9월 25일 오늘의 역사 (0) | 2025.09.24 |